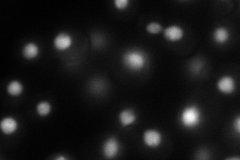
YNL124W

View description
RNA-binding protein required for the assembly of box H/ACA snoRNPs and thus for pre-rRNA processing, forms a complex with Shq1p and interacts with H/ACA snoRNP components Nhp2p and Cbf5p; similar to Gar1p
Localization:
Intensity:
Fold change:
Significance:
-
C’ GFP library in SD

below threshold15.8 -
N' NOP1pr-GFP in SD
nucleus89.0459 -
N' TEF2pr-mCherry in SD

nucleus117.934 -
N' NATIVEpr-GFP in SD

nucleus24.8944 -
N' TEF2pr-VC and Cyto-VN in SD

punctate,nucleus53.7498 -
C’ GFP library in SD+DTT

cytosol17.441.1No -
C’ GFP library in SD+H2O2

cytosol17.681.11No -
C’ GFP library in Starvation Media

cytosol16.41.03No -
C’ GFP library on the background of Pup2-DaMP

below threshold -
C’ GFP library on the background of CCT mutant

below threshold16.26761.02918No
